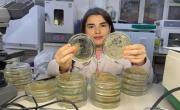

|
ОфициальноКазбек Коков встретился с выдающимися спортсменами и тренерами республикиГлава КБР Казбек Коков провел встречу с выдающимися спортсменами и тренерами республики.30 декабря, 09:24 | |
31 декабря, 12:00
|  В канун Нового года в Кабардино-Балкарском государственном аграрном университете имени В.М. Кокова прошла торжественная церемония вручения дипломов выпускникам третьего по счёту потока проекта «... |
29 декабря, 13:10
|  В стенах Кабардино-Балкарского музея изобразительных искусств имени А. Л. Ткаченко прошла необычная встреча любительского литературного объединения «Книга для своих».
|
29 декабря, 13:06
|  Для команды «Воскановцы» школы им. С. П. Восканова с. Пролетарского состоялось яркое и значимое событие - круглый стол «Мосты дружбы» с командой активистов движения «Первые Ростовановцы». Оно стало... |
НОВОСТИ РЕСПУБЛИКИ
Год защитника Отечества31 декабря, 10:05 |  |
Победа будет за нами!Указом Президента Российской Федерации В.В. Путина знаком отличия Ордена Святого Георгия – Георгиевским Крестом IV степени награждён участник специальной военной операции Аслан... |
Год защитника Отечества31 декабря, 09:03 |  |
Спасибо, сестричка!Оля Дурнева, уроженка станицы Подгорной Георгиевского района Ставропольского края, была большой любительницей литературы и мечтала стать учителем. |
Объявления30 декабря, 22:25 |  |
Парковка в Приэльбрусье на новогодних каникулахУважаемые жители и гости Эльбрусского района! |
Политика24 марта, 14:38 |  |
Научно-практический семинар по вопросам реабилитации детей с нарушением слухаВ рамках реализации мероприятий партийного проекта «Крепкая семья» в Республиканском детском клиническом многопрофильном центре Минздрава КБР прошёл семинар «Семья – основа... |
ЖКХ24 марта, 14:25 |  |
«Россети Северный Кавказ» сообщаетБолее миллиарда на инвестпрограмму «Россети Северный Кавказ» в минувшем году направили на реализацию инвестиционной программы филиала «Каббалкэнерго» более миллиарда рублей. |
Закон24 марта, 13:56 |  |
Наказание будет отбывать в колонии строгого режимаВ ходе реализации оперативно-разыскных мероприятий по противодействию незаконному обороту наркотических средств сотрудниками УФСБ России по КБР во взаимодействии с МВД по КБР... |
Год защитника Отечества24 марта, 13:55 |  |
Верхне-Силезская наступательная операцияВо второй половине февраля 1945 года армии правого крыла 1-го Украинского фронта с выходом на реки Одер и Нейсе почти на 200 км опередили объединения, действовавшие на его левом... |
Культура23 марта, 18:56 |  |
Праздник чтения и патриотизмаВсероссийская Неделя детской и юношеской книги – ежегодное событие, направленное на повышение интереса подрастающего поколения к литературе. |
Год защитника Отечества23 марта, 18:51 |  |
Служили два товарищаВ шестидесятых годах прошлого столетия в доме моего деда по материнской линии Сафарбия Мусовича гостил тогдашний председатель колхоза «Москва» в селении Жемтала Советского (ныне... |
Закон21 марта, 17:54 |  |
Полиция сообщаетЗадержали двоих «чёрных лесорубов» Сотрудники управления уголовного розыска МВД по КБР задержали двоих жителей Лескенского и Урванского районов, подозреваемых в незаконной рубке... |
Закон21 марта, 16:35 |  |
Отдельные счета для каждого совладельцаС 21 марта собственникам квартир с долевой собственностью начнут приходить отдельные квитанции по ЖКХ. |
Закон21 марта, 16:31 |  |
От штрафов к аресту автомобиляВ отделении судебных приставов по Урванскому и Лескенскому районам УФССП России по КБР в отношении местного жителя возбуждено около 70 административных штрафов за нарушения... |
Культура21 марта, 16:15 |  |
И будет жив мой крайВ Музее изобразительных искусств им. А.Л. |
Культура21 марта, 13:50 |  |
Замкнутый кругКакая ночь! Как улицы тихи! Двенадцать на часах Аэрофлота. И кажется - дойдёшь до поворота И потекут бессмертные стихи! Александр Галич |
Год защитника Отечества21 марта, 13:17 |  |
Народный памятник из монетПредставьте себе: старая деревянная шкатулка, покрытая пылью времени, а в ней – советские копейки и рубли, бережно хранимые вашими родителями. |
Мы вместе21 марта, 13:01 |  |
Очередной гуманитарный груз от Народного фронта КБР готов к отправке на передовуюОчередная партия гуманитарной помощи, собранная неравнодушными жителями и представителями Народного фронта в Кабардино-Балкарии, готовится к отправке на передовую. |
Закон21 марта, 13:00 |  |
Что растёт на вашей земле?В марте вступил в силу закон, согласно которому собственники участков обязаны начать их осваивать в течение трёх лет с момента покупки. |
Закон21 марта, 12:59 |  |
Оперативным штабом в КБР проведены учения по пресечению теракта20 марта Оперативным штабом в Кабардино-Балкарской Республике проведено плановое антитеррористическое учение. |
Страницы
- « первая
- ‹ предыдущая
- …
- 152
- 153
- 154
- 155
- 156
- …
- следующая ›
- последняя »
СОЦИУМ
Социум31 декабря, 14:13 |  |
Движущая сила для решения важных задачЗаместитель генерального директора по развитию ООО «ВоенТекстильПром» Темрук Аталиков – один из ключевых руководителей и проводников социальной миссии компании, его деятельность – яркий пример... |
Социум31 декабря, 12:11 |  |
Мадина Сатушиева – спортсмен годаПо давней традиции «КБП» определила самого успешного спортсмена уходящего 2025 года. Им стала воспитанница заслуженного тренера РФ по тхэквондо Амира Ахметова, чемпионка мира и сурдлимпийских игр по... |
Социум31 декабря, 12:08 |  |
Химики КБГУ – в числе лидеров отечественной наукиДостойный вклад в отечественную науку внесли учёные Кабардино-Балкарии, и в первом ряду – результаты, полученные специалистами Кабардино-Балкарского госуниверситета им. Х. М. Бербекова. |
Социум27 ноября, 16:33 | |
В родном доме и микроорганизмы помогаютУчёные центра декарбонизации АПК и региональной экономики КБГУ работают над важным инновационным проектом, в рамках которого намерены получить удобрение нового поколения на основе микроорганизмов,... |
Социум27 ноября, 16:31 |  |
Общественники проинспектировали дорожные объектыВзаимодействие с населением - неотъемлемая часть реализации национального проекта «Безопасные качественные дороги». |
Социум27 ноября, 16:28 |  |
Продолжается ремонт детского сада в Кременчуг-КонстантиновскомВ селе капитально ремонтируют единственный детский сад. Работы начаты благодаря региональному проекту по модернизации системы дошкольного образования. |
Социум27 ноября, 15:42 |  |
Отметили отличившихся сотрудниковВо время рабочей поездки в Кабардино-Балкарскую Республику главный судебный пристав РФ Дмитрий Аристов провёл оперативное совещание в Управлении ФССП России по КБР. |
Социум27 ноября, 13:11 |  |
Капитан бизнесаСегодня исполняется 65 лет Хисе Назировичу Беккаеву, талантливому менеджеру и организатору, президенту федерации горнолыжного спорта и сноуборда КБР, заместителю генерального директора АО «Кавказ.РФ». |
Социум27 ноября, 12:36 |  |
В Нальчике приступили к капремонту улицВ столице Кабардино-Балкарии начали ремонтировать несколько улиц. Капитальный ремонт будет произведён на улицах Головко (Каменская), Щорса, Кешокова и Ногмова. |
Социум26 ноября, 16:09 |  |
УФСИН сообщаетОбщественные наблюдатели посетили следственный изолятор В рамках Всероссийского дня правовой помощи детям члены Общественной наблюдательной комиссии КБР посетили следственный изолятор № 1 УФСИН... |
Социум26 ноября, 16:02 |  |
Вести из БаксанаЧемпион провёл открытую тренировку По инициативе местного отделения «Движения Первых» в одном из фитнес-клубов в Баксане прошла открытая тренировка по смешанному боевому единоборству. |
Социум26 ноября, 15:48 |  |
Его имя занесено в Книгу рекордов ГиннесаЖизнь в профессии и профессия в жизни – так можно сказать о моём бывшем учителе физкультуры, а в настоящем - доценте кафедры физической культуры и спорта КБГУ, кандидате педагогических наук,... |
Социум26 ноября, 15:46 |  |
Полиция сообщаетПравовая лекция для школьников Правовая лекция для учащихся 8-9 классов прошла в нальчикской школе № 19. |
Социум26 ноября, 12:41 |  |
Дороги обновляют по нацпроектуЗа шесть лет в Терском районе Кабардино-Балкарии привели в норматив более 50 км автодорог. |
Социум26 ноября, 12:40 |  |
93 километра автодорог за шесть летВ Урванском районе Кабардино-Балкарии за последние шесть лет привели в нормативное состояние десять автодорог общей протяжённостью 93 км. |
Социум26 ноября, 12:37 |  |
Соблюдайте меры пожарной безопасности!С наступлением отопительного сезона необходимо уделять ещё больше внимания вопросам пожарной безопасности при обращении с газовым оборудованием, электрическими приборами и печным отоплением |
Социум25 ноября, 18:37 |  |
Вести из БаксанаОчередная партия гуманитарного груза В Баксане собрали очередную партию гуманитарного груза для участников СВО, который будет доставлен на этой неделе. |
Социум25 ноября, 18:35 |  |
Полиция сообщаетПравовая помощь детям В Кабардино-Балкарии проведён Всероссийский день правовой помощи детям, организованный Управлением Министерства юстиции РФ по КБР. |
Страницы
- « первая
- ‹ предыдущая
- …
- 152
- 153
- 154
- 155
- 156
- …
- следующая ›
- последняя »






















